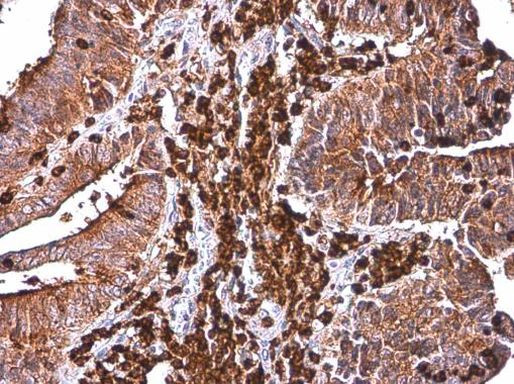
CYBA Antibody in Immunohistochemistry (Paraffin) (IHC (P))

Search
Invitrogen
CYBA Polyclonal Antibody
{{$productOrderCtrl.translations['antibody.pdp.commerceCard.promotion.promotions']}}
{{$productOrderCtrl.translations['antibody.pdp.commerceCard.promotion.viewpromo']}}
{{$productOrderCtrl.translations['antibody.pdp.commerceCard.promotion.promocode']}}: {{promo.promoCode}} {{promo.promoTitle}} {{promo.promoDescription}}. {{$productOrderCtrl.translations['antibody.pdp.commerceCard.promotion.learnmore']}}
产品信息
PA5-77937
种属反应
宿主/亚型
分类
类型
抗原
偶联物
形式
浓度
规格
纯化类型
保存液
内含物
保存条件
运输条件
RRID
产品详细信息
Positive Control: K562, THP-1, HL-60
Predicted Reactivity: Dog (100%)
Store product as a concentrated solution. Centrifuge briefly prior to opening the vial.
靶标信息
Cytochrome b is comprised of a light chain (alpha) and a heavy chain (beta). This gene encodes the light, alpha subunit which has been proposed as a primary component of the microbicidal oxidase system of phagocytes. Mutations in this gene are associated with autosomal recessive chronic granulomatous disease (CGD), that is characterized by the failure of activated phagocytes to generate superoxide, which is important for the microbicidal activity of these cells.
仅用于科研。不用于诊断过程。未经明确授权不得转售。
篇参考文献 (0)
生物信息学
蛋白别名: cytochrome b light chain; Cytochrome b(558) alpha chain; cytochrome b(558) alpha-subunit; cytochrome b, alpha polypeptide; Cytochrome b-245 light chain; cytochrome b-245, alpha polypeptide; Cytochrome b558 subunit alpha; flavocytochrome b-558 alpha polypeptide; Neutrophil cytochrome b 22 kDa polypeptide; p22 phagocyte B-cytochrome; p22-phox; p22phox; Superoxide-generating NADPH oxidase light chain subunit; unnamed protein product
基因别名: CGD4; CYBA; p22-PHOX
UniProt ID: (Human) P13498
Entrez Gene ID: (Human) 1535